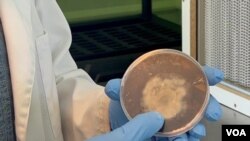
เชื้อเห็ดป่าในจานเพาะ

ในแต่ละปี ภาวะไฟป่าทั่วโลกทวีความรุนแรงขึ้นอย่างต่อเนื่อง และสถานการณ์ที่ว่าก็เกิดขึ้นกับพื้นที่ป่าไม้ในรัฐโคโลราโด ทางฝั่งตะวันตกของสหรัฐฯ ด้วย จนทำให้เจ้าหน้าที่ป่าไม้ในภูมิภาคดังกล่าวต้องทำงานเพื่อลดความเสี่ยงของการเกิดไฟป่าให้ได้
และวิธีที่เจ้าหน้าที่นำมาใช้ก็คือ การถางป่าและการตัดกิ่งหรือต้นให้พื้นที่ป่าลดลง
แต่เศษไม้และท่อนไม้ที่ถูกทิ้งไว้ในป่านั้นอาจกลายเป็นเชื้อไฟได้อย่างไม่ยาก ขณะที่ การขนย้ายออกไปจากป่าก็มีค่าใช้จ่ายสูง
ดังนั้น เจ้าหน้าที่ป่าไม้ที่อยู่นอกเมืองโบลเดอร์จึงทดสอบวิธีการทำให้เศษไม้แห้งเหล่านี้สลายตัวไปอย่างรวดเร็วด้วยวิธีการทางธรรมชาติ และนั่นก็คือ การใช้เห็ดเชื้อรานั่นเอง
แอรอน ครอปเลย์ เจ้าหน้าที่ป่าไม้ที่เมืองโบลเดอร์กล่าวว่า เศษไม้บางส่วนที่หลงเหลืออยู่ในป่าได้ถูกบริจาคไปให้กับโครงการเพาะเห็ดเพื่อใช้ทดลองการบรรเทาอัคคีภัยแล้ว
การเพาะเชื้อเห็นที่ว่านั้นเกิดขึ้นที่ศูนย์ศึกษาเกี่ยวกับเชื้อราและเห็ด Boulder Mushroom ซึ่งก่อตั้งโดย แซค เฮดสตอร์ม
เฮดสตอร์ม กล่าวว่า ทางศูนย์ทำการเพาะเลี้ยงเห็ดป่าที่มีอยู่ตามธรรมชาติไว้ในห้องทดลอง เพื่อศึกษาหาวิธีการใช้ประโยชน์จากพันธุ์เห็ดทั้งหลาย
ตัวอย่างของประโยชน์ที่ว่า มีอาทิ กรณีที่ไฟป่าร้อนจัดสามารถฆ่าเชื้อจุลินทรีย์ในดินจนทำให้มีความเสี่ยงของการเกิดดินถล่มได้ง่าย ซึ่งเฮดสตอร์มกล่าวว่า ต้นอ่อนต่าง ๆ จะเติบโตขึ้นมาพร้อม ๆ กับทำให้พื้นที่ที่มีปัญหาดังกล่าวกลับมามีสภาวะทรงตัวได้ดีกว่า หากมีการนำเห็ดเชื้อรามาผสมในดินด้วย เพราะเชื้อราไมคอร์ไรซาลช่วยให้พืชสามารถแบ่งปันน้ำและแบ่งปันสารอาหารให้กันและกันได้
อย่างไรก็ดี การฟื้นฟูป่าพื้นที่หนึ่งเฮกตาร์ หรือราว 6 ไร่นั้นอาจต้องใช้เชื้อราจำนวนมาก
ดังนั้น เพื่อที่จะทำให้มีปริมาณเชื้อราที่เพียงพอ ทีมงานของเฮดสตอร์มจึงได้เติมเชื้อราในปริมาณเล็กน้อยลงในถุงดินสำหรับปลูกหลายร้อยถุง และภายในเวลาไม่กี่วัน ถุงเพาะพันธุ์เหล่านั้นก็เต็มไปด้วย “ราก” ของเชื้อราไมซีเลียมเพื่อเตรียมพร้อมสำหรับการใช้เพื่อการบรรเทาปัญหาไฟป่า
ทั้งนี้ เศษไม้ที่อยู่ในป่ามักเป็นเป้าหมายของการใช้เห็ดเชื้อราเพื่อสู้ไฟป่า อย่างที่เมืองเอเวอร์กรีน รัฐโคโลราโด เศษไม้กองโต ๆ ก็คือความเสี่ยงการเกิดไฟป่าที่รอวันปะทุได้เป็นเวลานานหลายทศวรรษ ด้วยเหตุนี้ เจ้าหน้าที่ป่าไม้ เจฟ ราเวจ จึงตัดสินใจเร่งกระบวนการย่อยสลายของเศษไม้ด้วยการใช้เห็ดป่าที่มีอยู่ในธรรมชาติท้องถิ่น
ราเวจ กล่าวว่า กระบวนการที่ว่าใช้เวลาเพียงสองปีก็สามารถย่อยสลายเศษไม้กองยักษ์ได้ แต่ถ้าหากปล่อยให้กระบวนการดังกล่าวเกิดขึ้นตามธรรมชาติ ก็คงต้องใช้เวลาถึง 20 ถึง 50 ปี ดังนั้น เห็ดจึงเป็นเหมือนตัวเร่งปฏิกิริยาให้เกิดขึ้นได้เร็วกว่าปกติถึงกว่า 10 เท่า
เจ้าหน้าที่ป่าไม้รายนี้กล่าวต่อไปว่า การใช้เชื้อราในป่าในท้องถิ่นเพื่อกำจัดวัชพืชทั้งหลายนั้นเป็นสิ่งที่สำคัญ เพื่อป้องกันกรณีของการรุกรานโดยพืชต่างถิ่น
การค้นพบนี้ทำให้กลุ่มผู้บุกเบิกการบรรเทาการเกิดไฟป่าด้วยเห็ดเชื้อราหวังที่จะขยายความพยายามดังกล่าวให้มีการใช้งานมากขึ้น เพื่อช่วยเหลือประชาชนที่ต้องเผชิญกับภัยคุกคามจากไฟป่าให้รอดพ้นจากความเสี่ยงนี้ให้ได้
- ที่มา: วีโอเอ

กระดานความเห็น